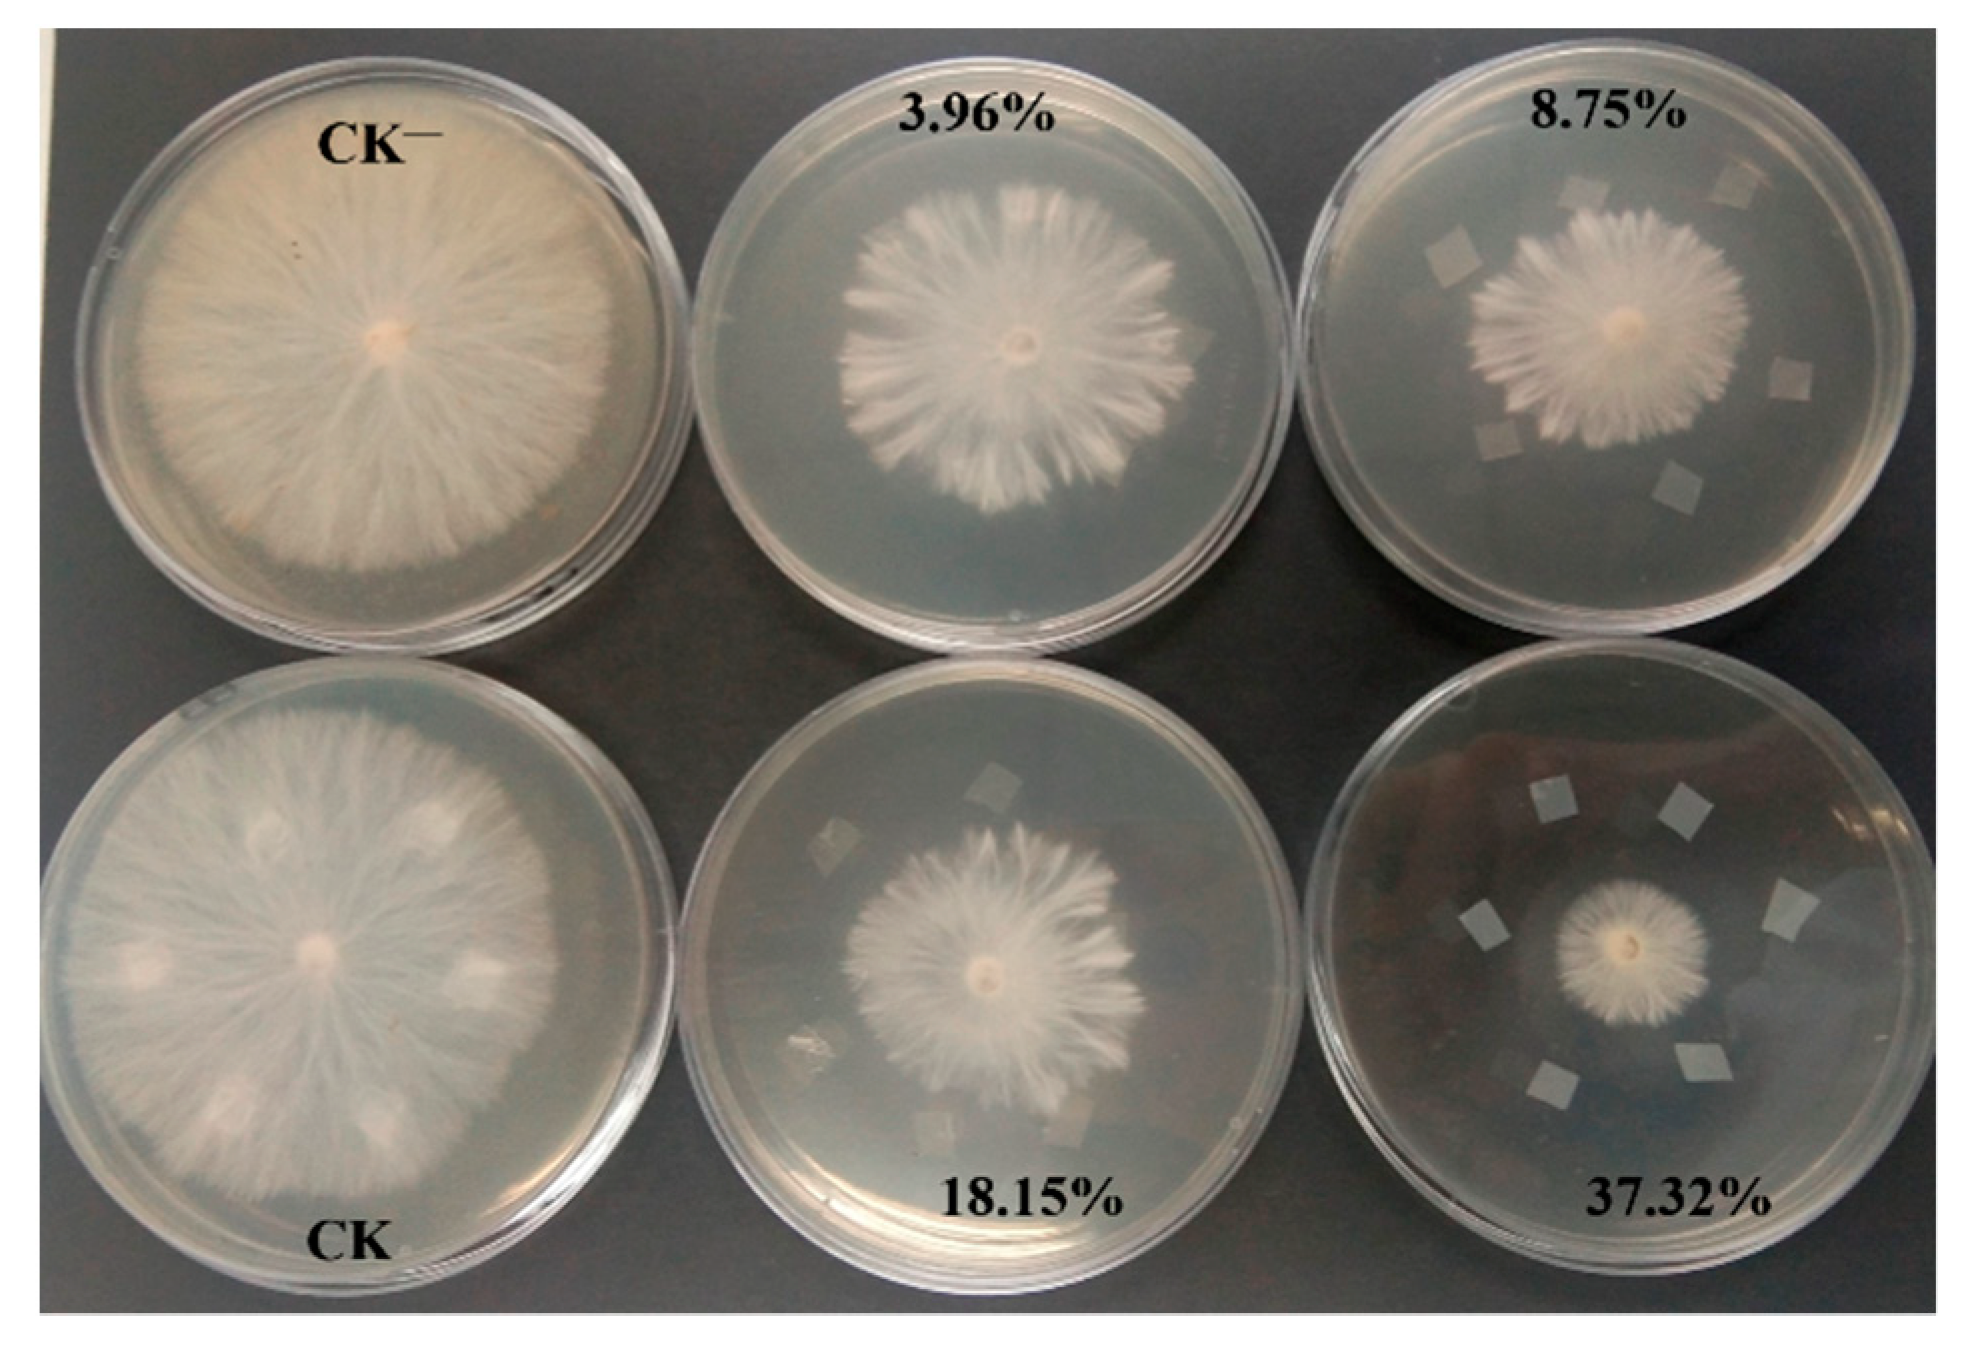

Effective and Sustained Control of Soil-Borne Plant Diseases by Biodegradable Polyhydroxybutyrate Mulch Films Embedded with Fungicide of Prothioconazole
Abstract
1. Introduction
2. Results and Discussion
2.1. Film Characterization
2.1.1. Film Thickness
2.1.2. Mechanical Properties
2.1.3. Water Solubility and Contact Angle
2.1.4. SEM Analysis
2.1.5. FT-IR Analysis
2.1.6. Optical Properties
2.2. Release and Release Kinetics Studies
2.3. Antifungal Properties and Pot Experiment
3. Materials and Methods
3.1. Materials
3.2. Preparation of PHB/PRO Composite Films
3.3. Determination of Actual peSticide Loading in Different Composite Films
3.4. Characterization of Composite Films
3.4.1. Film Thickness
3.4.2. Mechanical Properties
3.4.3. Scanning Electron Microscopy
3.4.4. Water Solubility
3.4.5. Contact Angle
3.4.6. FT-IR Spectroscopy
3.4.7. Film Transmittance and Transparency
3.5. Films Release and Release Kinetics Under Different pH
3.6. In Vitro Antifungal Properties
3.7. Pot Experiment
4. Conclusions
Author Contributions
Funding
Institutional Review Board Statement
Informed Consent Statement
Data Availability Statement
Conflicts of Interest
Sample Availability
References
- Pascual, J.A.; Rozas, M.M.; Rojo, M.A.D.; Ros, M. Soil fungicides to control soil-borne diseases of Mediterranean crops grown under greenhouse. Acta Hortic. 2020, 1268, 179–186. [Google Scholar] [CrossRef]
- Núñez-Zofío, M.; Larregla, S.; Garbisu, C. Application of organic amendments followed by soil plastic mulching reduces the incidence of Phytophthora capsici in pepper crops under temperate climate. Crop Prot. 2011, 30, 1563–1572. [Google Scholar] [CrossRef]
- Gelsomino, A.; Petrovičová, B.; Zaffina, F.; Peruzzi, A.C. Chemical and microbial properties in a greenhouse loamy soil after steam disinfestation alone or combined with CAO addition. Soil Biol. Biochem. 2010, 42, 1091–1100. [Google Scholar] [CrossRef]
- Samtani, J.B.; Gilbert, C.; Weber, J.B.; Subbarao, K.V.; Goodhue, R.E.; Fennimore, S.A. Effect of steam and solarization treatments on pest control, strawberry yield, and economic returns relative to methyl bromide fumigation. HortScience 2012, 47, 62–70. [Google Scholar] [CrossRef]
- Brodhagen, M.; Goldberger, J.R.; Hayes, D.G.; Inglis, D.A.; Marsh, T.L.; Miles, C. Policy considerations for limiting unintended residual plastic in agricultural soils. Environ. Sci. Policy 2017, 69, 81–84. [Google Scholar] [CrossRef]
- Bilck, A.D.; Grossmann, M.V.E.; Yamashita, F. Biodegradablemulch films for strawberry production. Polym. Test. 2010, 29, 471–476. [Google Scholar] [CrossRef]
- Hakkarainen, M.; Albertsson, A.C. Environmental degradationof polyethylene. Adv. Polym. Sci. 2004, 169, 177–200. [Google Scholar]
- Sander, M. Biodegradation of polymeric mulch films in agricultural soils: Concepts, knowledge gaps, and future research directions. Environ. Sci. Technol. 2019, 53, 2304–2315. [Google Scholar] [CrossRef]
- Reddy, C.S.K.; Ghai, R.; Kalia, V.C. Polyhydroxyalkanoates: An overview. Bioresour. Technol. 2003, 87, 137–146. [Google Scholar] [CrossRef]
- Volova, T.; Prudnikova, S.; Boyandin, A.; Zhila, N.; Kiselev, E.; Shumilova, A.; Baranovskiy, S.; Demidenko, A.; Shishatskaya, E.; Thomas, S. Constructing slow-release fungicide formulations based on poly(3-hydroxybutyrate) and natural materials as a degradable matrix. J. Agric. Food Chem. 2019, 67, 9220–9231. [Google Scholar] [CrossRef]
- Prudnikova, S.V.; Boyandin, A.N.; Kalacheva, G.S.; Sinskey, A.J. Degradable polyhydroxyalkanoates as herbicide carriers. J. Polym. Environ. 2013, 21, 75–682. [Google Scholar] [CrossRef][Green Version]
- Grillo, R.; Pereira, A.d.E.S.; de Melo, N.F.S.; Porto, R.M.; Feitosa, L.O.; SergioTonello, P.; Filho, N.L.D.; Rosa, A.H.; Lima, R.; Fraceto, L.F. Controlled release system for ametryn using polymer microspheres: Preparation, characterization and release kinetics in water. J. Hazard. Mater. 2011, 186, 1645–1651. [Google Scholar] [CrossRef] [PubMed]
- Boyandin, A.N.; Zhila, N.O.; Kiselev, E.G.; Volova, T.G. Constructing slow-release formulations of metribuzin based on degradable poly(3-hydroxybutyrate). J. Agric. Food Chem. 2016, 64, 5625–5632. [Google Scholar] [CrossRef] [PubMed]
- Volova, T.G.; Zhila, N.O.; Vinogradova, O.N.; Nikolaeva, E.D.; Kiselev, E.G.; Shumilova, A.A.; Shershneva, A.M.; Shishatskaya, E.I. Constructing herbicide metribuzin sustained-release formulations based on the natural polymer poly-3-hydroxybutyrate as a degradable matrix. J. Environ. Sci. Health B. 2016, 51, 113–125. [Google Scholar] [CrossRef] [PubMed]
- Volova, T.; Zhila, N.; Vinogradova, O.; Shumilova, A.; Prudnikova, S.; Shishatskaya, E. Characterization of biodegradable poly-3-hydroxybutyrate films and pellets loaded with the fungicide tebuconazole. Environ. Sci. Pollut. Res. 2016, 23, 5243–5254. [Google Scholar] [CrossRef]
- Chauhan, B.S.; Abugho, S.B. Integrated use of herbicide and crop mulch in suppressing weed growth in a dry-seeded rice system. Am. J. Plant Sci. 2013, 4, 1611–1616. [Google Scholar] [CrossRef]
- Khan, H.; Kaur, S.; Baldwin, T.C.; Radecka, I.; Jiang, G.; Bretz, I.; Duale, K.; Adamus, G.; Kowalczuk, M. Effective control against broadleaf weed species provided by biodegradable PBAT/PLA mulch film embedded with the herbicide 2-methyl-4-chlorophenoxyacetic acid (MCPA). ACS Sustain. Chem. Eng. 2020, 8, 5360–5370. [Google Scholar] [CrossRef]
- Liang, W.; Zhao, Y.; Xiao, D.; Cheng, J.; Zhao, J. A biodegradable water-triggered chitosan/hydroxypropyl methylcellulose pesticide mulch film for sustained control of Phytophthora sojae in soybean (Glycine max L. Merr.). J. Clean. Prod. 2020, 245, 118943. [Google Scholar]
- Jacob, S.; Sajjalaguddam, R.R.; Sudini, H.K. Streptomyces sp. RP1A-12 mediated control of peanut stem rot caused by Sclerotium rolfsii. J. Integr. Agric. 2018, 17, 892–900. [Google Scholar] [CrossRef]
- Casida, J.E.; Durkin, K.A. Pesticide chemical research in toxicology: Lessons from nature. Chem. Res. Toxicol. 2017, 30, 94–104. [Google Scholar] [CrossRef]
- Sinuo, T.; Miaomiao, T.; Zhiyuan, M.; Sen, Y.; Ming, J.; Ruisheng, L.; Li, L.; Jin, Y.; Zhiqiang, Z.; Wentao, Z. Toxicity effects in zebrafish embryos (Danio rerio) induced by prothioconazole. Environ. Pollut. 2019, 255, 113269. [Google Scholar]
- Zhang, Z.; Gao, B.; Li, L.; Zhang, Q.; Xia, W.; Wang, M. Enantioselective degradation and transformation of the chiral fungicide prothioconazole and its chiral metabolite in soils. Sci. Total Environ. 2018, 634, 875–883. [Google Scholar] [CrossRef] [PubMed]
- Liu, R.; Xu, Z.; Chen, C.; Huang, Y.; Liang, W.; Ge, X.; Ge, J. Effects of modified SWCNT on the mechanical and thermal properties of PLA/PHB biocomposites. AIP Adv. 2020, 10, 075122. [Google Scholar] [CrossRef]
- Altaee, N.; El-Hiti, G.A.; Fahdil, A.; Sudesh, K.; Yousif, E. Biodegradation of different formulations of polyhydroxybutyrate films in soil. SpringerPlus 2016, 5, 762. [Google Scholar] [CrossRef] [PubMed]
- Zhang, Y.-L.; Wang, F.-X.; Shock, C.; Yang, K.-J.; Kang, S.-Z.; Qin, J.-T.; Li, S.-E. Effects of plastic mulch on the radiative and thermal conditions and potato growth under drip irrigation in arid Northwest China. Soil Tillage Res. 2017, 172, 1–11. [Google Scholar] [CrossRef]
- Korsmeyer, R.W.; Gurny, R.; Doelker, E.; Buri, P.; Peppas, N.A. Mechanisms of solute release from porous hydrophilic polymers. Int. J. Pharm. 1983, 15, 25–35. [Google Scholar] [CrossRef]
- Cao, L.; Liu, Y.; Xu, C.; Zhou, Z.; Zhao, P.; Niu, S.; Huang, Q. Biodegradable poly(3-hydroxybutyrate-co-4-hydroxybutyrate) microcapsules for controlled release of trifluralin with improved photostability and herbicidal activity. Mater. Sci. Eng. C 2019, 102, 134–141. [Google Scholar] [CrossRef]
- Wen, X.; Lu, X. Microbial degradation of poly(3-hydroxybutyrate-co-4-hydroxybutyrate) in soil. J. Polym. Environ. 2012, 20, 381–387. [Google Scholar] [CrossRef]
- Sequeira, R.A.; Dubey, S.; Pereira, M.M.; Maity, T.K.; Singh, S.; Mishra, S.; Prasad, K. Neoteric solvent systems as a sustainable media for dissolution and film preparation of poly-[(R)-3-hydroxybutyrate]. ACS Sustain. Chem. Eng. 2020, 8, 12005–12013. [Google Scholar] [CrossRef]
- Merino, D.; Gutiérrez, T.J.; Mansilla, A.Y.; Casalongué, C.A.; Alvarez, V.A. Critical evaluation of starch-based antibacterial nanocomposites as agricultural mulch films: Study on their interactions with water and light. ACS Sustain. Chem. Eng. 2018, 6, 15662–15672. [Google Scholar] [CrossRef]
- Woggum, T.; Sirivongpaisal, P.; Wittaya, T. Properties and characteristics of dual-modified rice starch based biodegradable films. Int. Biol. Macromol. 2014, 67, 490–502. [Google Scholar] [CrossRef] [PubMed]

Publisher’s Note: MDPI stays neutral with regard to jurisdictional claims in published maps and institutional affiliations. |
© 2021 by the authors. Licensee MDPI, Basel, Switzerland. This article is an open access article distributed under the terms and conditions of the Creative Commons Attribution (CC BY) license (http://creativecommons.org/licenses/by/4.0/).
Share and Cite
Chen, G.; Cao, L.; Cao, C.; Zhao, P.; Li, F.; Xu, B.; Huang, Q. Effective and Sustained Control of Soil-Borne Plant Diseases by Biodegradable Polyhydroxybutyrate Mulch Films Embedded with Fungicide of Prothioconazole. Molecules 2021, 26, 762. https://doi.org/10.3390/molecules26030762
Chen G, Cao L, Cao C, Zhao P, Li F, Xu B, Huang Q. Effective and Sustained Control of Soil-Borne Plant Diseases by Biodegradable Polyhydroxybutyrate Mulch Films Embedded with Fungicide of Prothioconazole. Molecules. 2021; 26(3):762. https://doi.org/10.3390/molecules26030762
Chicago/Turabian StyleChen, Ge, Lidong Cao, Chong Cao, Pengyue Zhao, Fengmin Li, Bo Xu, and Qiliang Huang. 2021. "Effective and Sustained Control of Soil-Borne Plant Diseases by Biodegradable Polyhydroxybutyrate Mulch Films Embedded with Fungicide of Prothioconazole" Molecules 26, no. 3: 762. https://doi.org/10.3390/molecules26030762
APA StyleChen, G., Cao, L., Cao, C., Zhao, P., Li, F., Xu, B., & Huang, Q. (2021). Effective and Sustained Control of Soil-Borne Plant Diseases by Biodegradable Polyhydroxybutyrate Mulch Films Embedded with Fungicide of Prothioconazole. Molecules, 26(3), 762. https://doi.org/10.3390/molecules26030762

